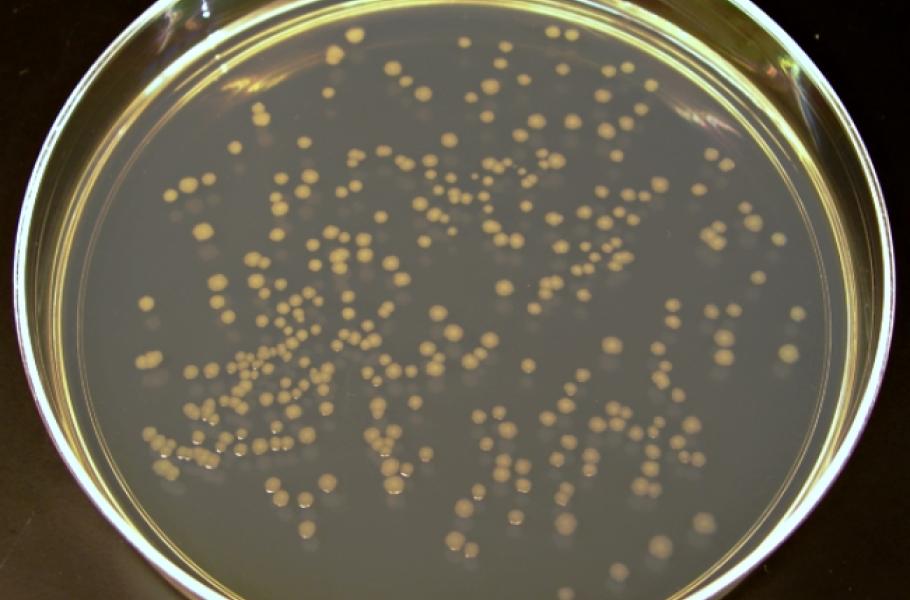

Vědci chtějí vyměnit E. coli za nejrychleji rostoucí bakterii na světě
Dojde ke střídání na pozici nejužitečnější bakterie ve vědeckých laboratořích?
Pokud by mezi bakteriemi byla superstar, tak to nepochybně je Escherichia coli. Žádná jiná bakterie se tak často a intenzivně nevyužívá ve vědeckém výzkumu a právě jí vděčíme za mnohé zásadní poznatky.
Proč je tak oblíbená? Bakterie E. coli se snadno množí, v ideálním živném médiu se počet jejich buněk zdvojnásobí za 20 minut. Hlavním důvodem je ale historie jejího výzkumu – o žádné jiné bakterii toho tolik nevíme. Proto si vědci E. coli rádi vybírají do svých experimentů, mají na co navazovat. Mezi odborníky se ale šíří názory, že je možná na čase udělat na postu laboratorní superstar změnu.
TIP: Zachrání nás před vražednými bakteriemi bakteriální superhrdinové?
Genetici z Harvardu navrhují nahradit E. coli bakterií Vibrio natriegens, která pochází z bahna přímořských slanisek. Je blízce příbuzná slavnému původci cholery, narozdíl od něj ale není lidem nebezpečná. A proč zrovna tahle bakterie? Důvod je jednoduchý – množí se nejrychleji ze všech známých bakterií. Počet buněk Vibrio natriegens se zdvojnásobí za těžko uvěřitelných 10 minut.